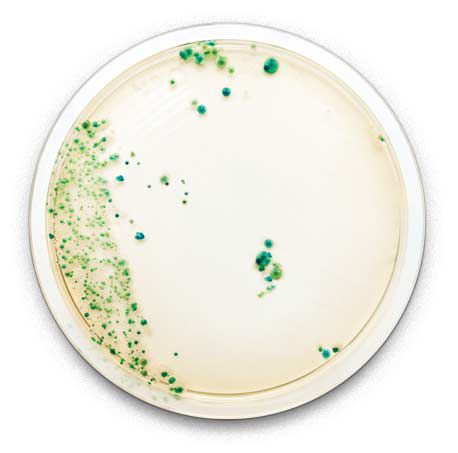
Tedlar® film does not support or provide nutrients to assist in mold and bacteria growth

Tedlar™ Wallcoverings are protected by a film that provides an impervious barrier against stains, making it easy to wipe away everything from permanent marker to iodine.

- Cleaners & Bleach
Tedlar® film can stand up to the harshest industrial cleaning products, including bleach and alcohol-based solvents. It is even unaffected by strong acids, bases and acetone.

- Fire & Smoke
Tedlar® film has low smoke ratings and does not readily burn or support combustion, making it one of the safest materials designed for interiors.
Durable when it matters most.
All collections are GREENGUARD Gold certified for improved indoor air quality. Our wallcoverings also are Health Product Declaration® verified. They have been proven for more than 30 years of use, which means you can feel confident that your design will look flawless many years later.
All of our products are made in America and kept in stock. So whenever you need material, we have you covered.

How clean and comfortable should look
Whatever space they grace, Tedlar™ Wallcoverings make a strong – and lasting – first impression. The Tedlar™ surface delivers unparalleled performance in even the most rigorous environments through proven durability and stain and scuff resistance.

Your vision. Our performance.
DuPont™ Tedlar® Film has over 30 years of proven performance in some of the harshest environments. From resisting weathering on solar panels to keeping airplane interiors looking clean and new, DuPont™ Tedlar® Film provides incomparable durability for your design.
We work closely with our clients to provide custom samples within 1-2 weeks. And just because it is custom doesn’t mean you have to wait to get your material. We manufacture custom orders within 4-6 weeks.
3 decades and counting.
DuPont™ Tedlar® film has been protecting interior walls in the Omega Medical Center in Newark, DE for more than 30 years.

Tried and tested durability.
DuPont™ Tedlar® Film has been a trusted provider of protective solutions in commercial applications for over 50 years.
Learn more about how Tedlar® Film provides unparalleled interior and exterior architectural protection at:

Your Vision. Our Performance.
In addition to being available in a variety of colors and patterns,
Tedlar™ Wallcoverings can be customized to meet your design needs.
Have an idea?